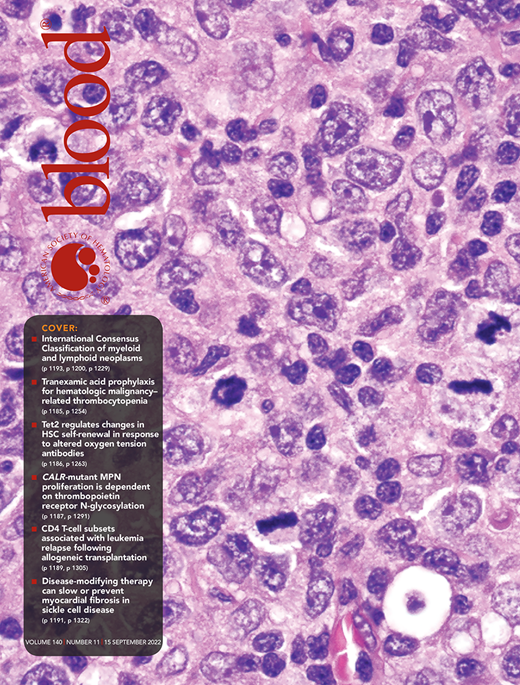
Blood Cover Image for Volume 140, Issue 11

Errors were introduced into Figures 2 and 6 during the publication process. The publisher apologizes for these errors, which have been corrected in the online version of the article.
On page 1469, in Figure 2A, the purple label “MILE B-ALL (GSE13159)” should be in olive type. In Figure 2B, the dark blue, purple, medium green, and bright red bars should be light blue, olive, light green, and pale red, respectively, and the pale blue background color in the headings and graphs should be light gray. In Figure 2D, the percentages in the plots should be in black type, not blue type.
The corrected Figure 2 is shown below.
On page 1475, in the diagram labeled “Mixture file COG B-ALL (GSE11877)” in Figure 6A, a small gray oval was incorrectly placed outside the illustration of a blood vessel. The corrected Figure 6A is shown below.
The online version of the article was inadvertently published without the visual abstract. The visual abstract has been added to the online article.